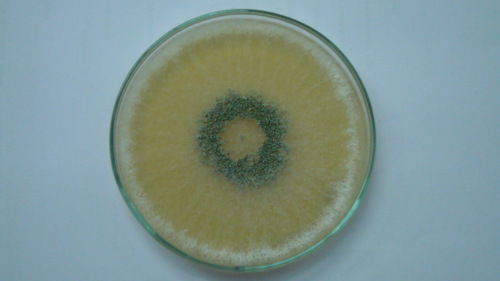
Potato Dextrose Agar

Fresh Organic Potatoes - Chopped, Cooked Style | A Grade Fresh Vegetables, Common Shape, Brown Color
Price: 16 INR / Kilograms
Get Latest Price
Minimum Order Quantity :
500 Kilograms
In Stock
Product Specifications
| Style | Cooked |
| Shape | Common |
| Processing Form | Chopped |
| Payment Terms | Paypal, Cash Advance (CA), Cash in Advance (CID) |
| Supply Ability | 5000 Per Week |
| Delivery Time | 2 Days |
| Sample Policy | Contact us for information regarding our sample policy |
| Packaging Details | As per industrial standard |
| Main Domestic Market | All India |
Product Overview
Key Features
Condition : Fresh
Application : Food
Country of Origin : India
Color : Brown
Type : Fresh Vegetables
Company Details
Focusing on a customer-centric approach, SHREE BALAJI AGENCIES has a pan-India presence and caters to a huge consumer base throughout the country. Buy Fresh Vegetables in bulk from SHREE BALAJI AGENCIES at Trade India quality-assured products.
Business Type
Supplier
Working Days
Monday To Sunday
Related Products
Explore Related Categories
More Products From This Seller
Seller Details
New Delhi, Delhi
Manager
Mr. Ak Das
Address
RZ-I/15, Mahavir Enclave Old Som Bazar Road, New Delhi, Delhi, 110045, India
Report incorrect details